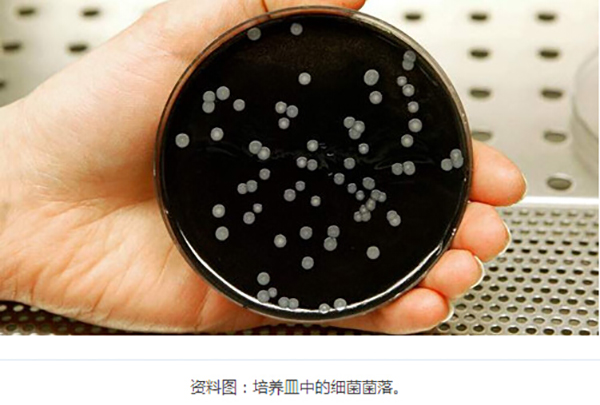

疯狂女粉丝入侵男星家 被抓时正裸身洗澡(组图)
日期:2016-01-18 09:53:21 阅读: 来源:凤凰网
监控摄像拍到该女赤身裸体 1月16日,MIC男团成员赵泳鑫的经纪人刘奕辰以“艺人的善良不是让你放肆的资本”为题发布长微博,称疯狂女粉丝非法入侵赵泳鑫家,被家中监控摄像拍到,警察入屋抓人发现该女赤身裸体
 |
监控摄像拍到该女赤身裸体
1月16日,MIC男团成员赵泳鑫的经纪人刘奕辰以“艺人的善良不是让你放肆的资本”为题发布长微博,称疯狂女粉丝非法入侵赵泳鑫家,被家中监控摄像拍到,警察入屋抓人发现该女赤身裸体的躺在艺人家中的浴缸里洗澡。
赵泳鑫称该女生还盗取自己的微信,潜入自己家中使用生活用品,使用浴缸,让自己非常气愤和崩溃。
 |
私生饭非法入侵MIC男团赵泳鑫家中
刘奕辰微博原文:
现在是1月16日凌晨4:40分,四个小时前我陪小鑫从警局录完口供出来,现在心情很复杂,对于昨天晚上发生的一系列事情仍然是乍舌到无法理解。
1 月15日下午两点多,小鑫来公司开专辑企划会之前给我打来一个电话,说昨晚临睡觉前听到门口的电子锁一直发出声音,也不知道什么情况,我说一定要注意安全,怕是年关前会有小偷想要入室盗窃,他说没事,待会出门把家里的一个监控摄像头打开可以用手机随时远程监控,未成想到,摄像头的开启,抓住的不是入室小偷,而是一个让人心有余悸的不速之客。现在想想,实属万幸,如若不是我们在手机远程监控到这位不速之客进屋之后的种种迅速报警,而是小鑫在晚上独自回到家,没有任何心理准备的情况下发现这位不速之客,那后果我不敢想象。
晚上18:53分,开会的间隙,小鑫打开了手机远程监控系统,忽然看到家中出现的不速之客,当下我们立刻决定报警处理,我陪同小鑫立刻从公司赶往他家,在此很感谢警察同志的出警速度,我们到达小鑫家的时候警察与小区安保都已在门口等待,打开房门之后,发生的一系列事情再一次刷新了我的三观。
进门之后警察挨个房间查看,最终发现此女赤身裸体躺在卧室卫生间的浴缸里,画面之诡异令人发指,现场所有警察都惊讶了,说办案这么多年,还第一次看到非法入侵能这么淡定自在的,我不抨击你的受教育程度,只想说做为一个女生,你连最基本的自尊自爱都没有。
在去到警局之前,警察对此女做了简单的问话,她的狡辩之词让人觉得幼稚与可笑,当下她可能还没有意识到她的这个行为已经触犯法律,到了警局之后,我打电话咨询公司律师相关事宜,也知晓我们有权提告并追究其法律责任。
当民警跟她宣读刑法第245条有关“非法入侵住宅罪”相关条例,并向分局汇报案件情况时,她开始惊慌开始道歉开始求情,她哭诉她知道错了,她真心道歉,保证以后不再犯了,她不想留案底,希望小鑫能原谅她,不要追究这些责任。
我们与警察商讨了很久,我坚持追究到底,因为之前此女就曾做出骚扰跟踪艺人、非法进入艺人演出入住酒店房间、盗取艺人微博账号、微信账号、网络信息等恶劣行为。但小鑫却一直安抚我的愤怒,说如果这次的事件真的能让她得到教训,长了记性,不再犯了,愿意给她一次改过的机会,放弃追究其法律责任,如果这次让她留下案底,那可能对她以后的生活都会造成影响。
事情的大概经过我写了下来,只是希望小鑫又一次大度的原谅能让某位不速之客真正意识到自己的行为是有多么的不堪和无耻,多么的让人恶心和恐惧,请记住,艺人的善良不是你用来放肆的资本,好自为之。
版权声明
1. 未经《新西兰天维网》书面许可,对于《新西兰天维网》拥有版权、编译和/或其他知识产权的任何内容,任何人不得复制、转载、摘编或在非《新西兰天维网》所属的服务器上做镜像或以其他任何方式进行使用,否则将追究法律责任。
2. 在《新西兰天维网》上转载的新闻,版权归新闻原信源所有,新闻内容并不代表本网立场。
-

- 男子到女友家洗鸳鸯浴被电身亡 女友被弹出(图)
- 时间:2016-01-05 09:38:28
- 相关新闻
-

- 香港男星后悔接拍三级片:拍后工作机会都没有了
- 时间:2015-11-09 14:55:21
- 相关新闻
-

- 南岛奇葩盗窃案:想偷东西,进屋后忽然想洗个澡
- 时间:2015-10-26 09:41:06
- 相关新闻
-
- 坚持12年不洗澡 美国科学家为了搞科研也是拼了
- 时间:2015-09-07 10:53:04
- 相关新闻
-

- Spark脑洞大开 防水手机支架让“厕所歌手”想唱就唱
- 时间:2015-07-14 15:13:23
- 相关新闻
-

- 手机偷拍他人洗澡 奥克兰背包客旅馆现“色情狂”
- 时间:2015-06-14 09:19:36
- 相关新闻
-

- 英最胖男子重八百多斤 无法自己洗澡需他人帮助(图)
- 时间:2015-05-04 10:58:37
- 相关新闻
-

- 美国华裔模特裸身彩绘地球图案呼吁素食(组图)
- 时间:2015-04-22 10:11:52
- 相关新闻
-

- 男星自曝过去10年如后宫戏 不记得睡过多少女人
- 时间:2015-04-12 10:13:56
- 相关新闻
-

- 自己老婆也不能随便拍 NZ男子偷拍妻子洗澡被起诉
- 时间:2015-04-08 09:02:04
- 相关新闻
- 天维导航频道,了解您生活的方方面面:
- 想知道新西兰有什么样的福利吗?想知道关于新西兰的百科知识吗?新西兰都有哪些热门网站?点击这里,您就知道!
- Follow我们的新浪微博
- 您想第一时间了解新西兰的新闻吗?请您访问//weibo.com/skykiwidotcom,从今天开始关注我们吧!
- 纽惠康 - 源于新西兰的健康体验
- 纽惠康是天维网旗下唯一的购物网站,我们的宗旨是利用我们的品牌优势,以最优惠的价格为您提供新西兰最优质的健康产品。请访问//wellcome.co.nz















